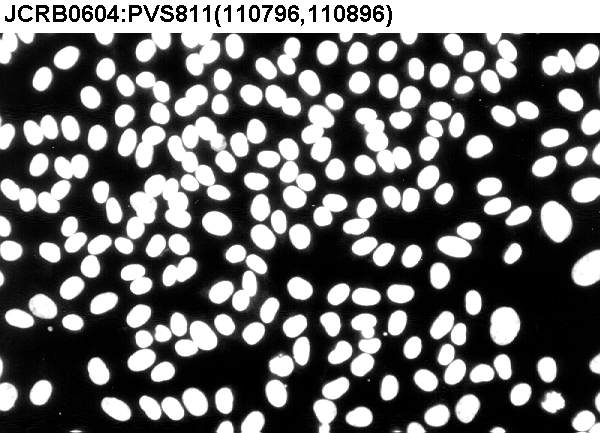

JCRB0604 PSV811
Cell information
Important Notice(s)JCRB0604 PSV811 is derivative from WI-38.
| JCRB No. | JCRB0604 | Cell Name | PSV811 |
|---|---|---|---|
| Profile | Stop providing for the issue of quality control. (Please contact us for more information) This cell line was originally beleived to be derived from werner's syndrom but identified as same as WI38. | Other Name | |
| Animal | human | Strain | |
| Genus | Homo | Species | sapiens |
| Sex | Age | ||
| Identity | available | Tissue for Primary Cancer | skin |
| Case history | originally thought to be a werver's syndrome. | Metastasis | |
| Tissue Metastasized | Genetics | skin | |
| Life Span | Crisis PDL | ||
| Morphology | Character | skin, werner's syndrome | |
| Classify | mutant | Established by | Matsumura,T. |
| Registered by | Kuroki,T. | Regulation for Distribution | Distribution allowed after papers are published. |
| Comment | Year | ||
| Medium | Eagle's minimal essential medium with 10% fetal bovine serum | Methods for Passages | Cells are treated with 0.02% EDTA and 0.25% trypsin |
| Cell Number on Passage | 1-2x10^4 cells/cm^2 | Race | Japanese |
| CO2 Conc. | 5 % | Tissue Sampling | skin |
| Tissue Type |
| Detection of virus genome fragment by Real-time PCR | |||||||||
|---|---|---|---|---|---|---|---|---|---|
| Detected DNA Virus | tested | Detected RNA Virus | not tested | ||||||
| CMV | - | parvoB19 | - |
-/negative. +/positive. nt/not tested. (positive (+) does not immediately mean the production of infectious viral particles.) |
|||||
| EBV | - | HBV | - | ||||||
| HHV6 | - | HTLV-1 | - | ||||||
| HHV7 | - | HTLV-2 | - | ||||||
| BKV | - | HIV-1 | - | ||||||
| JCV | - | HIV-2 | - | ||||||
| ADV | - | HPV18 | NT | ||||||
| Notes | |||||||||
| Reference | |
|---|---|
| Pubmed id:3002148 | Studies of SV40-infected Werner syndrome fibroblasts. Matsumura T,Nagata M,Konishi R,Goto M Adv Exp Med Biol. 1985;190():313-30 |
| Pubmed id:6301867 | Decrease in the average size of replicons in a Werner syndrome cell line by Simian virus 40 infection. Hanaoka F,Takeuchi F,Matsumura T,Goto M,Miyamoto T,Yamada M Exp Cell Res. 1983 Apr 1;144(2):463-7 |
| Images |
|---|
![]() ![]() ![]() ![]() ![]() ![]() ![]() ![]() ![]() ![]() ![]() |
LOT Information
Viability/Growth rate/Cell number are represented as actual values measured at lot presentation in JCRB, but are not guaranteed values. Additionally, the doubling time is a rough value measured during passages.| Cell No. | JCRB0604 | Cell Name | PSV811 |
|---|---|---|---|
| LOT No. | 110896 | Lot Specification | distribution |
| Medium | Eagle's minimal essential medium with 10% fetal bovine serum (JRHB 1B1062). | Temperature | 37 C |
| Cell Density at Seeding | 1-2x10^4 cells/sq.cm. | Methods for Passages | Treat cells with 0.04% tripsin in PBS. |
| Doubling Time | NT | Cell Number in Vial (cells/1ml) | 1.7x10^6 |
| Viability at cell freezing (%) | 97.9 | Antibiotics Used | free |
| Passage Number | P3* | PDL | NT |
| Sterility: MYCOPLASMA | - | Sterility: BACTERIA | - |
| Sterility: FUNGI | - | Isozyme Analysis | NT |
| Chromosome Mode | NT | Chromosome Information | NT |
| Surface Antigen | NT | DNA Profile (STR) | |
| Adhesion | Yes | Exoteric Gene | NT |
| Medium for Freezing | Culture medium with 5% DMSO. | CO2 Conc. | 5 % |
| Viability immediately after thawing (%) | Additional information |
| Images |
|---|
![]() ![]() ![]() |
| Cell No. | JCRB0604 | Cell Name | |
|---|---|---|---|
| LOT No. | 900127 | Lot Specification | distribution |
| Medium | Eagle's minimal essential medium with 10% fetal bovine serum | Temperature | 37 |
| Cell Density at Seeding | Methods for Passages | EDTA , trypsin | |
| Doubling Time | Cell Number in Vial (cells/1ml) | ||
| Viability at cell freezing (%) | Antibiotics Used | ||
| Passage Number | PDL | ||
| Sterility: MYCOPLASMA | Sterility: BACTERIA | ||
| Sterility: FUNGI | Isozyme Analysis | ||
| Chromosome Mode | Chromosome Information | ||
| Surface Antigen | DNA Profile (STR) | ||
| Adhesion | Exoteric Gene | ||
| Medium for Freezing | CO2 Conc. | ||
| Viability immediately after thawing (%) | Additional information |
| Cell No. | JCRB0604 | Cell Name | |
|---|---|---|---|
| LOT No. | 911204 | Lot Specification | distribution |
| Medium | Eagle's minimal essential medium with 10% fetal bovine serum | Temperature | 37 |
| Cell Density at Seeding | Methods for Passages | EDTA , trypsin | |
| Doubling Time | Cell Number in Vial (cells/1ml) | ||
| Viability at cell freezing (%) | Antibiotics Used | ||
| Passage Number | PDL | ||
| Sterility: MYCOPLASMA | Sterility: BACTERIA | ||
| Sterility: FUNGI | Isozyme Analysis | ||
| Chromosome Mode | Chromosome Information | ||
| Surface Antigen | DNA Profile (STR) | ||
| Adhesion | Exoteric Gene | ||
| Medium for Freezing | CO2 Conc. | ||
| Viability immediately after thawing (%) | Additional information |